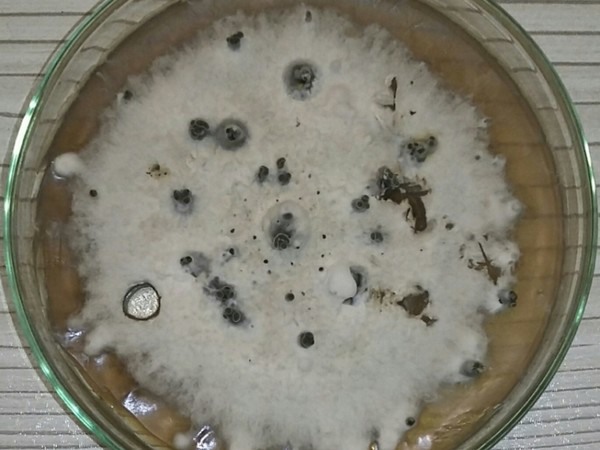

Ficus benjamina, commonly called weeping fig or Benjamin fig, is a flowering plant in the family Moraceae. It is widely grown as an ornamental tree or hedge. During the spring of 2019, yellowing and dieback of F. benjamina were observed in different regions of Hamedan Province, Iran (Fig. 1).

Figure 1: Yellowing and dieback on plants infected with Diaporthe foeniculina.
To isolate the causal organism from infected tissues, small twig pieces were cut from the boundary between diseased and healthy tissue, surface-sterilised for one minute in 1% (w/v) sodium hypochlorite, rinsed three times with sterile water, dried on sterile filter paper, transferred to potato dextrose agar (PDA; Merck, Darmstadt, Germany) and incubated at 25°C in the dark. Five to seven days after incubation, fungal isolates were obtained from symptomatic tissues. The morphological characteristics were determined based on pure cultures grown on PDA. Colony morphology, size and shape of 30 conidia and conidiophores were recorded after seven days incubation. Colonies on PDA were slow-growing and white with sparse aerial mycelium (Fig. 2). After 15 days, conidioma (pycnidium) production was observed (Fig. 3). Microscopic identification was done using a Leica DMLB microscope. Pycnidia globose to subglobose with an elongated and black neck. Conidiophores hyaline, sub-cylindrical and cylindrical, filiform, branched above the septa, tapering towards the apex, 1-3 septate, (19-)20-28(-32) × 2(-3) μm. Conidiogenous cells hyaline, subcylidrical and filiform, straight, slightly tapering towards the apex, collarette not flared, with prominent periclinial thickening, (10-)11-15(-17) × 2(-3) μm. Alpha conidia aseptate, hyaline, smooth, ellipsoidal or fusiform and 8-9 × 2-2.5 μm (Fig. 4a). Beta conidia aseptate, filiform, slightly curved and 25-29 × 1-1.5 μm (Fig. 4b). Based on morphological and cultural characteristics, the isolates were identified as Diaporthe foeniculina (Sacc.) Udayanga & Castl. (=Phomopsis foeniculina (Sacc.) Udayanga & Castl) (Udayanga et al., 2014). Representative cultures were deposited in the culture collection of the Iranian Research Institute of Plant Protection (IRAN3161C).
Figure 2: Colony morphology of Diaporthe foeniculina after 15 days on potato dextrose agar.

Figure 3: Stromatic structures of Diaporthe foeniculina after 15 days on potato dextrose agar.

Figure 4: a) Alpha-conidia and b) beta-conidia of Diaporthe foeniculina.
In order to confirm Koch's postulates, pathogenicity tests were performed on healthy seedlings in laboratory conditions at 25°C with natural daylight as follows. Stems were wounded using a sterile 5 mm diameter metal cork borer. A mycelial plug (5 mm diameter) obtained from the margin of a seven-day-old fungal colony (IRAN 3161C) was placed in the wound. The wound was wrapped with plastic film and for the control plants, a plug of clean PDA was placed in the wound. Two weeks after inoculation, symptoms were observed on the inoculated plants while no symptom appeared on the control. Diaporthe foeniculina was consistently reisolated from artificially infected plants (Fig. 5).

Figure 5: Control plant (left) and yellowing and dieback on an artificially infected plant (right).
To confirm the morphological identification, one isolate (IRAN 3161C) was selected for molecular analysis. Genomic DNA was extracted from mycelium of a pure culture as described by Sharma et al. (2002). Molecular identification was performed based on the beta-tubulin gene which was sequenced using primers BT2A and BT2B (Glass & Donaldson, 1995). BLAST search of a 566 bp sequence (GenBank Accession No. MG367462) showed 100% identity with D. foeniculina (KC843213). These test results confirmed D. foeniculina to be the causal agent of the newly observed disease on F. benjamina. To our knowledge, this is the first report of yellowing and dieback caused by D. foeniculina on F. benjamina (Farr & Rossman, 2020).
Source: BSPP (A. Esmaeilzadeh, D. Zafari and S. Bagherabadi)